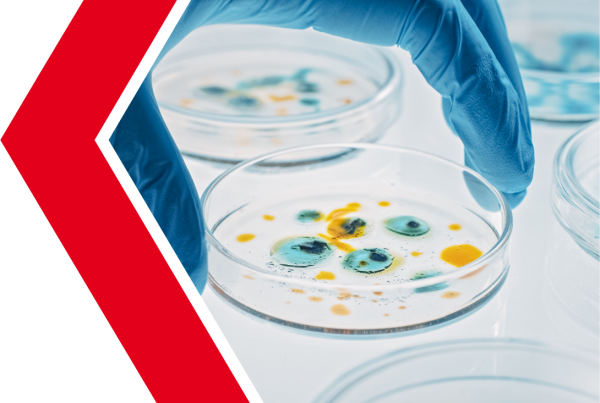
Votre bouteille d'eau est-elle vraiment propre ?

Votre bouteille d'eau est-elle vraiment propre ?
Une étude récemment commandée par waterfilterguru.com et publiée dans le New York Post en mars 2023 révèle que presque toutes les bouteilles rechargeables contiennent un nombre étonnamment élevé de GERMES, de BACTERIES GRAM-NEGATIVES ET MÊME D'ESCHIRIES COLI
un nombre étonnamment élevé de GERMES, de BACTÉRIES GRAM-NEGATIVES, de BACILIES ET MÊME D'ESCHIRIES COLI.
Plus précisément, il a été constaté que les flacons réutilisables contenaient :
- 40.000 fois plus de bactéries et de bacilles que sur la tablette d'eau ;
- Deux fois plus de bactéries et de bacilles que sur le comptoir de la CUISINE;
- 4 fois plus de bactéries et de bacilles que sur la souris de l'ordinateur ;
- 14 fois plus de bactéries et de bacilles que dans la gamelle du chien.

À quelle fréquence devez-vous remplacer votre bouteille d'eau ?
Il semble que laver et sécher souvent votre gourde ne suffise pas à éviter le risque de contact avec les germes et les bactéries :
il serait bon de le changer toutes les saisons....
- mais ce n'est qu'avec 12M que vous pouvez le faire
- sans produire de déchets et de plastique !!!
12M EST LA SEULE ÉCO-BOUTEILLE RÉUTILISABLE 100% COMPOSTABLE QUI SE DISSOUT COMPLÈTEMENT DANS L'ENVIRONNEMENT EN 12 MOIS SANS LAISSER DE TRACES ET SANS POLLUER

Pourquoi choisir 12M ?
CE N'EST QU'AVEC 12M, LA NOUVELLE BOUTEILLE ÉCOLOGIQUE CRÉÉE PAR ROTO, QUE VOUS POUVEZ PRENDRE SOIN DE VOTRE SANTÉ... ET DE LA PLANÈTE DANS LAQUELLE VOUS VIVEZ !
Notre éco-bouteille 12M est fabriquée en BAS 0332, un matériau plastique bio innovant composé d'éléments renouvelables d'origine végétale tels que des charges minérales naturelles et des produits de polymérisation de l'acide succinique obtenus à partir de la fermentation de la biomasse végétale.
Grâce à sa composition chimique unique, le BAS 0332 se dégrade en se dissolvant dans le sol en l'espace de 12 mois, sans libérer d'éléments toxiques et en se décomposant naturellement en eau, en oxygène et en dioxyde de carbone.
